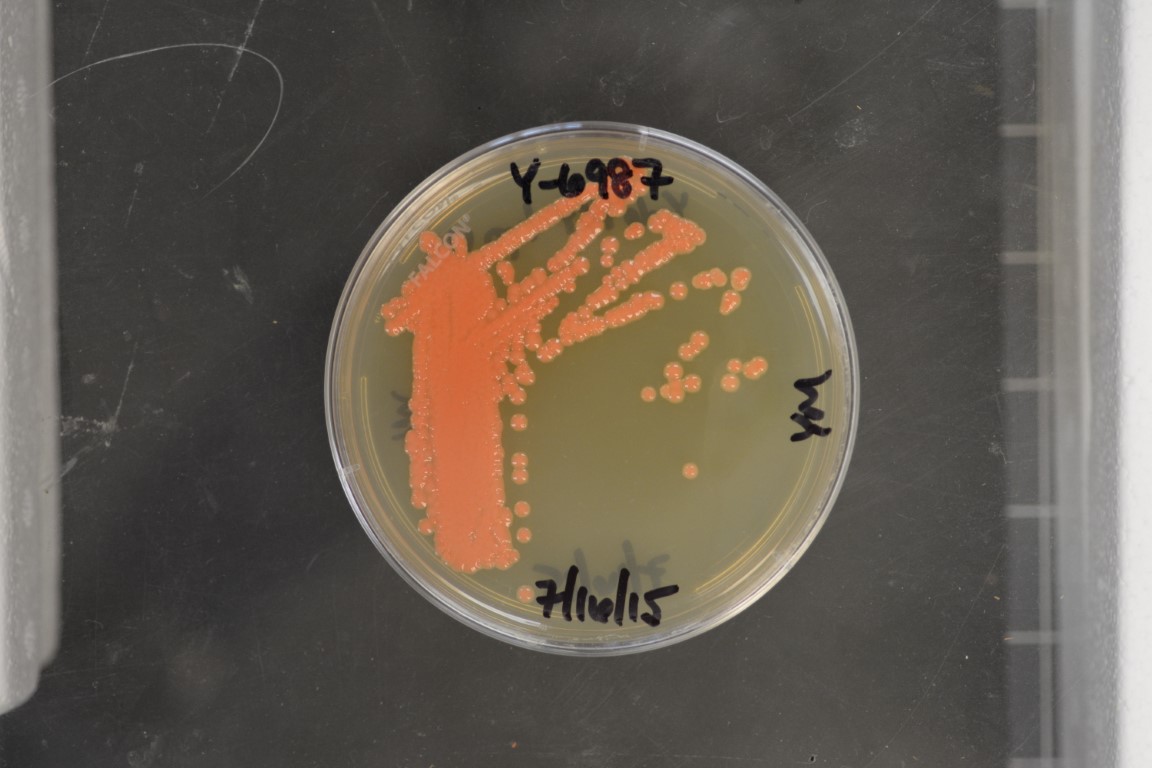

Rhodotorula toruloides
NRRL Y-6987(Type Strain)
Accession numbers in other collections:CBS 6016=IFO 11588=IFO 8766=IGC 5615=MUCL 28631=PYCC 5615
Source:Banno,Institute of Fermentation,Osaka,Japan
Isolated from(substrate):diploid,hyphal conjugate of NRRL Y-1091 x NRRL Y-1588
Genetic info:GUEHO RNA,0 diff.D2 with Y-27012 and Y-27013.
Growth media:Yeast Extract-Malt Extract-Peptone-Glucose(YM for yeasts)(number 6)
Optimum growth temperature:25C
Strain images:
NRRL_Y-6987_6.jpg
 Comments:MycoBank MB813358
Comments:MycoBank MB813358